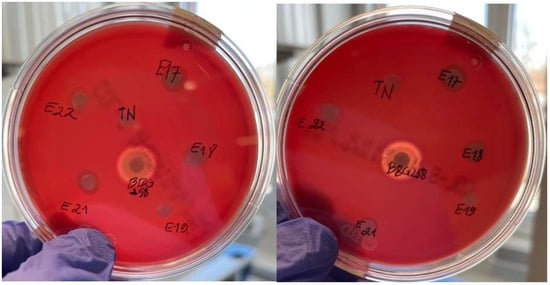

Abstract
This study assessed the performance and potential use of lactic acid bacteria (LAB) from Moroccan traditional foods as probiotics in animal feed. Five LAB strains Lactiplantibacillus plantarum from whey sourdough, Leuconostoc pseudomesenteroides and Leuconostoc mesenteroides from goat cheese, Enterococcus durans and Lacticaseibacillus casei from fermented milk were isolated and identified by 16S rRNA gene sequencing and MALDI-TOF mass spectrometry. Probiotic traits were evaluated by measuring acid/bile tolerance, cell surface hydrophobicity, emulsifying properties, antimicrobial activity and organic acid production, and safety checked through hemolysis and antibiotic sensitivity tests. L. plantarum, L. casei, and E. durans showed high survival rates after 24 h of culture under acid/bile stress conditions. The surface hydrophobicity of all strains ranged from 14.4 to 39.2%. L. plantarum showed the highest emulsifying capacity (81.4%) and stability (20%) after 24 h. Most strains inhibited pathogenic Staphylococcus epidermidis, Bacillus cereus, and Escherichia coli. Metabolite profiling revealed L. pseudomesenteroides as an interesting butyric acid-producing bacterium and L. plantarum as a remarkable strain releasing high content of organic acids. Their antibiotic susceptibility and non-hemolytic nature support their safety and potential use as feed additives.
1. Introduction
Growing environmental pressures and food safety issues are central concerns for scientists and society. It is no longer just a question of producing enough food, but also of ensuring that it is healthy, nutritious and free from contaminants [1]. A key challenge faced globally is the ability to satisfy rising demand for high-quality, nutrient-rich food while simultaneously safeguarding consumer health [2]. Simultaneously, the excessive and improper use of antibiotics as growth promoters or prophylactics in livestock has contributed to the emergence of antibiotic resistance in pathogenic microorganisms, including Escherichia coli, Salmonella enteritidis, Staphylococcus aureus and Bacillus cereus [3]. This resistance undermines the efficacy of antibiotics, posing a significant threat to both human and animal health [4].
Consequently, the European Union and USA implemented a prohibition on the uncontrolled use of antibiotic growth promoters (AGPs) [5], prompting increased interest in sustainable alternatives that benefit not only human health but also the environment, plants, and animals [6]. The reduction in antimicrobial usage in the agricultural sector presents a considerable opportunity, supporting a proposal to progressively eliminate their application as growth promoters [7,8]. Currently, extensive research endeavors are focused on identifying natural and sustainable solutions to mitigate the dual challenges of chemical residues and antibiotic resistance, thereby advancing the safety and sustainability of food and health systems [9]. Potential alternatives include the utilization of probiotics, which are live microorganisms that, when consumed in sufficient quantities, exert beneficial and regulatory effects on the microbiota, thereby influencing the host’s health positively [10]. The capacity of probiotics to enhance the balance of intestinal microbiota and barrier function, fortify the immune system, and contribute to the prevention of various diseases, is the subject of extensive global research. However, most studies predominantly focus on strains derived from products of European or Asian origin, leaving significant potential reservoirs of probiotics largely unexamined. Africa, with its remarkable cultural diversity and unique culinary traditions, represents a valuable yet underutilized source of probiotic strains [9,11,12]. Historically, these beneficial microorganisms have been isolated from healthy human hosts, animal, milk, and dairy products [12,13,14]. This concept has significantly advanced with the identification of novel probiotic strains in various fermented food and non-food products from diverse regions across the globe.
Africa is among the continents with the richest diversity of traditional fermented foods, which are of great importance regarding socio-economic growth, food security, nutrition, and health of African consumers [15]. In several African countries, fermented foods have been playing a pivotal role in food preservation and nutritional values, owing to the abundance of beneficial microbial populations with a wide range and multiple functionalities [16]. Nowadays, the progress in high-throughput DNA sequencing and proteomic technics for microbial identification can support the idea of screening food and non-food matrices from various African countries. In this context, our team has been focusing on potential material sources available in Morocco and in Western African countries for a collaborative work within the framework of the Horizon Europe URBANE project (www.urbane-project.eu/wp-urbane, accessed on 1 July 2022). The selection of these sources is guided by the Food and Agriculture Organization of the United Nations (FAO) and the World Health Organization (WHO) criteria, and fully in line with an approach to promote local biological resources and preserve a unique food and microbiological heritage, in accordance with the principles of sustainability and scientific sovereignty promoted under the Nagoya agreements [17]. In Morocco, as in West African countries, traditional fermented products are widely consumed by the population, especially in rural areas where the processes are still carried out according to ancestral practices transmitted locally. Due to the specific environmental conditions and the absence of industrialization, some food matrices in these regions likely contain endemic strains that have not yet been described. For instance, Moroccan cow milk often produced through back-slopping methods contains LAB strains with highly valuable properties and functionalities such as stress resistance and metabolite producing capacity [16].
The main purpose of this study was to identify and evaluate the LAB isolated from Moroccan food products (whey sourdough, goat cheese and fermented milk) by assessing their acid and bile tolerance, cell surface hydrophobicity, emulsifying capacity, antimicrobial activity, and production of short-chain fatty acids. The study also examines bacteria safety profiles, specifically their hemolytic activity and antibiotic susceptibility.
2. Materials and Methods
2.1. Sample Collection and Media Preparation
Samples were collected from three natural products (fermented milk, whey sourdough and goat cheese) provided by the Moroccan partner involved in the Horizon Europe URBANE project (https://urbane-project.eu/wp-urbane/, accessed on 1 July 2022). The raw materials were maintained at 4 °C during transport to the Faculty of Gembloux Agro-Bio Tech at the Terra Teaching and Research Centre in Belgium and were subsequently stored under the same conditions until further analysis. To isolate LAB strains based on their taxonomic group or genus, two selective culture media were used: De Man, Rogosa, and Sharpe (MRS) and M17 (Merck KGaA, 64271 Darmstadt, Germany) [18]. Media were prepared according to the manufacturer’s instructions. Calcium carbonate was added during the screening and isolation steps as an indicator of acid production. To avoid Maillard reactions during sterilization, glucose (20 g) was dissolved in 200 mL of distilled water and sterilized separately.
2.2. Isolation and Selection of LAB
One gram (1 g) of each sample of Moroccan natural products was diluted separately in 9 mL of sterile buffered peptone water. A series of successive dilutions was carried out and then spread on a Petri dish containing MRS or M17 agar medium following by incubation at 37 °C [18]. The LAB were isolated anaerobically in a jar [12] equipped with a deaerator (OxoidTM AnaeroGenTM 2.5 L, Oxoid Ltd, Wade Road, Basingstoke, RG24 8PW, United Kingdom by Mitsubishi Gas Chemical Company Inc., Tokyo, Japan) to obtain their optimal growth parameters. Following a 24 to 48 h incubation period at 37 °C, colonies exhibiting phenotypic variations in terms of appearance, coloration, and morphology are selected. These colonies were subsequently subcultured onto the appropriate solid medium to obtain pure isolates, thereby ensuring accurate and reliable identification results [19,20].
2.3. Bacterial Species Identification
16S rRNA Sequencing
Bacterial DNA was extracted using the NucleoSpin® Tissue Kit (Macherey-Nagel) in accordance with the manufacturer’s protocol for bacterial samples. The purity of 2 µL of the extracted DNA was assessed using a Nanodrop spectrophotometer by measuring absorbance at 260 and 280 nanometers (nm), with 2 µL of distilled water serving as the blank. The samples were then purified using the NucleoSpin® Gel and PCR Clean-up Kit (Macherey-Nagel, Düren, Germany). Subsequently, a polymerase chain reaction (PCR) was conducted utilizing Q5® High-Fidelity DNA Polymerase. The primer sequences utilized were as follows: 8F (5′-AGA GTT TGA TCC TGG CTC AG-3′) and 1492R (5′-ACG GTT ACC TTG TTA CGA CTT-3′). The thermal cycling program employed consisted of cycles comprising 10 s at 98 °C, 30 s at 62 °C, and 1 min at 72 °C [21]. Amplification products were verified by agarose gel electrophoresis and subsequently submitted to Eurofins Genomics for sequencing. Bacterial identification was carried out by comparing the resulting sequences to those in the GenBank database using the National Center for Biotechnology Information (NCBI) BLASTn algorithm.
2.4. Maldi-TOF Mass Spectrometry Analysis
Bacterial isolates were identified using matrix-assisted laser desorption/ionization time-of-flight mass spectrometry (MALDI-TOF MS) model Bruker Autoflex Speed TOF/TOF (Bruker Daltonics, Bremen, Germany). Only isolates exhibiting distinct morphological characteristics were subjected to identification by this method. Individual colonies were first purified through successive streaking on agar medium to ensure clonal homogeneity. For protein extraction, approximately 1 mg of biomass was collected from a fresh colony using a sterile toothpick and suspended in 200 µL of ultrapure water. Subsequently, 600 µL of absolute ethanol was added to the suspension, which was then centrifuged at 13,000× g for 3 min. The resulting pellet was air-dried in a 40 °C oven for 5 min. Cell lysis was achieved by resuspending the dried pellet in 50 µL of formic acid (70%), followed by the addition of 50 µL of acetonitrile. Then, the suspension was centrifuged at 13,000× g for 2 min, and 1.25 µL of the supernatant was spotted onto a designated MALDI-TOF target plate. The plate was allowed to dry under a laminar flow hood. An equal volume (1.25 µL) of a saturated α-cyano-4-hydroxycinnamic acid (HCCA) matrix solution (Bruker Daltonics) was then applied to each well to facilitate ionization. After air-drying at room temperature, the plate was inserted into the MALDI-TOF instrument for spectral acquisition using FlexControl version 3.4 software. Mass spectra were recorded and analyzed using the manufacturer’s integrated software (FlexAnalysis version 3.4, 2021) and reference databases (MBT Compass reference library, 2021) [22]. Each isolate yielded a logarithmic score ranging from 0 to 3. According to the manufacturer’s guidelines, scores ≥ 2.300 indicate a highly probable species-level identification. Scores between 2.000 and 2.299 correspond to a secure genus-level identification and a probable species-level identification. Scores ranging from 1.700 to 1.999 are considered indicative of a probable genus-level identification, whereas scores < 1.700 are regarded as unreliable for taxonomic identification. Here, the identification is mainly based on the identification of ribosomal proteins that are very abundant in all microorganisms. The characteristic motifs of these proteins are compared with those stored in a large database, to determine the identity of the microorganism down to the species level [21].
2.5. Assessment of Resistance to Acid and Bile Salt
Acid and bile salt tolerance assays were conducted to evaluate the physiological robustness of the LAB isolates under gastrointestinal-like stress conditions. The assays were performed in MRS broth adjusted to pH 2.5 and 3.0 using 1 M sulfuric acid and supplemented with bile salts (Sigma-Aldrich Chemie GmbH, Steinheim, Germany) at final concentrations of 0.5% and 1.0% (w/v), in accordance with previously described protocols [23,24]. Bacterial growth under normal conditions (pH 6.5 without stress) was monitored over a 24 h period using a TECAN Spark® multimode microplate reader. For this condition, 200 µL of the adjusted MRS broth standardized to an initial optical density (OD600) of 0.1 was aliquoted into individual wells of a sterile 96-well microplate. The microplates were incubated at 37 °C under anaerobic conditions, with continuous double orbital shaking (amplitude: 1 mm; frequency: 270 rpm). Optical density at 600 nm was automatically recorded every 20 min throughout the incubation period to assess bacterial growth kinetics under normal conditions.
After 4 h of culture in MRS broth supplemented with 0.5% or 1.0% (w/v) in acid conditions (pH 2.5 and 3) with a total volume of 10 mL in a flack of 100 mL, viability was determined by counting viable colonies on MRS agar incubated at 37 °C for 24 h in each stress condition and compared to the control (MRS pH 6.5), as described by Sakoui et al., 2024 [25].
2.6. Antimicrobial Activity
The antagonistic activity of the LAB isolates was assessed using an agar disk diffusion assay to evaluate their antibacterial potential. Briefly, a volume of 100 μL of each standardized indicator strains (106 CFU·mL−1) was evenly spread onto Mueller–Hinton agar plates (Sigma-Aldrich, Darmstadt, Germany). Once the surface of the agar had dried, sterile Whatman paper disks were placed onto the medium, and 10 μL of each LAB young culture (108 CFU·mL−1) were carefully deposited onto the disks and then incubated at 37 °C for 24 h. The selected indicator strains Bacillus cereus, Staphylococcus aureus, and Escherichia coli were obtained from the Terra Laboratory. Following 24 h of incubation at 37 °C, antibacterial activity was evidenced by the formation of clear inhibition zones (halos) around the disks. The diameter of each zone was measured in millimeters (mm) and interpreted as follows: no inhibition (<1 mm), weak inhibition (2–8 mm), moderate inhibition (8–16 mm), and strong inhibition (>16 mm) [26,27]. The results were divided as follows: no inhibition (<1), weak inhibition (2–8 mm), moderate inhibition (8–16 mm), and strong inhibition (>16 mm).
Antibacterial activity was also evaluated using the agar well diffusion method as mentioned by Arrioja-Bretón et al., 2020 [28]. In brief, indicator strains (Escherichia coli, Bacillus cereus, and Staphylococcus epidermidis) were cultured in nutrient broth to ~106 CFU/mL and incorporated into molten Mueller–Hinton agar. Wells (8 mm) were aseptically punched and filled with 100 µL of cell-free supernatants (CFS) to measure only the influence of extracellular metabolites of LAB. Then, the supernatants were neutralized with 4 M NaOH to eliminate the influence of organic acids, acidification and hydrogen peroxides. Plates were incubated at 37 °C for 24 h, and antimicrobial activity was determined by measuring the diameter of the inhibition zones around the wells (mm). The neutralized cell-free supernatants (NCFS), which exhibited antagonistic effects against indicator strains, were considered as potentially producing bacteriocins or bacteriocin-like compounds. All experiments were performed in triplicate, and results are presented as mean ± SD (standard deviation).
2.7. pH Measurement
The pH of LAB cultures was measured to evaluate their acidifying capacity, a key criterion of probiotic potential and antimicrobial activity. The selected strains (Lactobacillus plantarum (E17), Leuconostoc mesenteroides (E19), Leuconostoc pseudomesenteroides (E18), Enterococcus durans (E21), and Lactobacillus casei (E22)) were grown in MRS broth at 37 °C for 24 h. Aliquots were collected at 0, 6, 12, and 24 h. pH was determined using a calibrated pH meter, standardized with buffer solutions at pH 4.0 and 7.0 prior to each measurement series. All measurements were performed in triplicate.
2.8. Surface Hydrophobicity Measurement
Surface hydrophobicity of isolated LAB was evaluated using the MATS (Microbial Adhesion To Solvent) method as originally described by Rosenberg et al., 1980 [29] subsequently modified by other researchers [30,31]. Toluene was employed as the hydrophobic solvent for this assessment. LAB were cultivated overnight in MRS broth devoid of Tween 80 (Sigma-Aldrich, Buchs, Suisse) to avoid interference of surfactants with solvent-water interfacial tension [30]. Cells were harvested at the late exponential phase and then centrifugated at 5000× g for 10 min at 4 °C, washed twice with sterile phosphate-buffered saline (PBS, pH 7.0), and resuspended in the same buffer. The optical density (OD600) of suspension was adjusted to 1.0 using a VWR-V 1200 spectrophotometer, corresponding to an approximate cell density of 108 CFU·mL−1. For each assay, 1 mL of toluene was added to 3 mL of bacterial suspension in sterile glass tubes. The mixtures were vigorously vortexed for 3 min and then allowed to stand undisturbed at room temperature for 20 min to facilitate phase separation [30]. Following incubation, the aqueous phase was carefully collected, and its absorbance at 600 nm was measured. The extent of bacterial adhesion to the hydrocarbon phase was determined by comparing the OD600 values before and after mixing. Surface hydrophobicity was calculated using the following Equation (1).
Equation (1): Percentage of surface hydrophobicity of LAB strains [30].
2.9. Organic Acids Production
To quantify short-chain fatty acids (SCFAs) produced by the LAB strains, cultures were grown in MRS broth at 37 °C for 18 h. Following incubation, the cultures were centrifuged at 5000× g for 15 min at 4 °C to collect the cell-free supernatants. A volume of approximately 1 mL of each supernatant was then filtered through 0.22 μm pore-size membrane filters (Millipore, St. Louis, MO, USA) to remove residual particulates. The concentrations of organic acids were determined using high-performance liquid chromatography (HPLC; Agilent 1200 Series, Agilent Technologies, Santa Clara, CA, USA). Chromatographic separation was performed using a suitable column (Aminex® HPX-87H 300 mm length × 7.8 mm diameter, Bio-Rad, Hercules, CA, USA) and a mobile phase consisting of 5 mM sulfuric acid at a flow rate of 0.6 mL/min. Detection was carried out using refractive index detector (RID). An injection volume of 15 μL was employed for each sample, with a total run time of 35 min per analysis. Quantification of organic acids was performed through peak area integration using Agilent OpenLab CDS version 2.3 software. The results were expressed in terms of concentration based on calibration curves generated from authenticated standards analyzed under identical chromatographic conditions. This analytical approach enabled the identification and quantification of major SCFAs, such as lactic, acetic, butyric, and malic acids, produced during fermentation, this allowed metabolic profiling of the LAB strains [32,33].
2.10. Emulsion Index (EI)
Emulsion index was determined according to the method described by Prasanna et al., 2012 [34], with modifications. A volume of 5 mL of cell-free supernatant was mixed with 5 mL of toluene in a sterile glass screw-cap tube (100 mm × 13 mm) and vortexed vigorously for 1 min to ensure thorough homogenization. The assay was performed in triplicate. The emulsifying activity was assessed by determining the emulsion index (EI), expressed as a percentage. Emulsion height was measured at less than 1 h (initial emulsion stability) and after 24 h (long-term stability), using the following Equation (2):
Equation (2): Emulsion Index measurement of culture supernatant.
Where he corresponds to the height of the emulsion and ht the total height of the sample and toluene mixture.
2.11. Antibiotic Susceptibility
Antibiotic susceptibility of the bacterial strains was evaluated using the disk diffusion method on Mueller–Hinton (MH) agar. An overnight culture in MRS broth was centrifuged, washed twice with sterile PBS, and adjusted to a final concentration of approximately 108 CFU·mL−1. The bacterial suspension was then evenly spread onto the surface of MH agar plates. After drying, six antibiotic disks (Neo-Sensitabs™, ROSCO, Taastrup, Denmark) were aseptically placed on the agar using a sterile antibiotic disk dispenser. The plates were incubated anaerobically at 30 °C for 24 h. Antibiotic susceptibility was determined by measuring the diameter of the clear zones of inhibition surrounding the disks. According to the interpretive criteria established by the Clinical and Laboratory Standards Institute (CLSI), strains exhibiting an inhibition zone diameter of less than 15 mm were classified as resistant (R), whereas those with a diameter equal to or greater than 15 mm were considered susceptible (S) to the tested antibiotic [35].
2.12. Hemolytic Activity
Hemolytic activity was assessed using Columbia agar supplemented with 5% (w/v) defibrinated sheep blood [36,37]. Actively growing bacterial cultures were centrifuged and washed twice with sterile PBS (pH 7). The resulting pellets were resuspended in 6 mL of PBS to achieve an optical density of 1 at 600 nm. A 10 µL aliquot of each bacterial suspension was spotted onto the blood agar plates. Bacillus subtilis BBG258 control [38] was used as a positive control, while sterile PBS (pH 7) served as the negative control. Plates were incubated at 37 °C for 48 h under aerobic conditions. Following the incubation, hemolytic activity was assessed by observing the lysis of red blood cells in the medium surrounding the colonies. Hemolysis was classified into three categories: (i) α-hemolysis, indicated by a greenish discoloration around the colony (partial hemolysis); (ii) β-hemolysis, indicated by a clear, transparent halo (complete hemolysis); and (iii) γ-hemolysis, characterized by the absence of any visible zone (non-hemolytic). Strains displaying γ-hemolysis were considered non-hemolytic and therefore regarded as safe for potential probiotic use [39]. For optimal visualization, hemolytic reactions were assessed by positioning the blood agar plates against a transmitted light source, allowing accurate differentiation of hemolysis types.
2.13. Statistical Analysis
Data preprocessing and analysis were performed, respectively, using Microsoft Excel 365® and GraphPad Prism® version 10.5.0 Software (Boston, MA, USA). All experiments were conducted in triplicate. Results are presented as mean values of the three replicates and one-way analysis of variance (ANOVA) was performed following by post hoc multiple comparison Tukey test. Differences were considered statistically significant when the decision threshold was set at p-value < 0.05.
3. Results
The characterization strategy described by Figure 1 follows a systematic, multi-step approach to comprehensively evaluate potential probiotic candidates, integrating both phenotypic and functional analyses. Initially, bacterial strains are cultivated under solid and liquid culture conditions to assess growth dynamics and purity. Strains were identified using molecular (e.g., 16S rRNA sequencing) and analytic (Maldi-TOF MS) techniques to confirm taxonomic status. The isolates with high score and percentage of identity were selected then tested for resistance to acid and bile salts to simulate gastrointestinal survival, an essential probiotic parameter. Functional screening includes assays for antibacterial activity against pathogens (e.g., by agar diffusion) and cell surface hydrophobicity measurements to infer the potential for adhesion to host epithelial cells. Further safety and efficacy assessments involve hemolytic activity tests (to exclude pathogenicity), antibiotic susceptibility profiling to ensure resistance patterns align with regulatory guidelines. The study of the hydrolase activity of bile salts related to cholesterol metabolism is highlighted by the evaluation of the emulsion index. Finally, the production of short-chain fatty acids (SCFAs) was quantified, as these metabolites contribute to gut health. This multi-layered strategy ensures a holistic assessment of the viability, safety and functionality of probiotics, in line with FAO/WHO standards for the characterization of probiotics [40].

Figure 1.
Mean steps for selection and characterization of potential probiotics.
3.1. Screening and Identification of the LAB Strains
The results of the identification indicate a diverse array of bacterial species present in both food and non-food products originating from Africa (Table 1). Five LAB isolates belonging to four genera were formally identified through both 16S rRNA gene fragment sequencing and MALDI-TOF mass spectrometry. The results indicate that the percentage identities for 16S rRNA identification range from 97% to 100%, while the scores obtained from MALDI-TOF MS fall between 2.02 and 2.37. The LAB identified are predominantly derived from fermented products, notably sourdough, fresh goat cheese, and fermented milk. Only five representative LAB species identified with the highest scores (≥2.000) and percentages of identity and showing the same bacterial species name on both sides were selected for further analysis.

Table 1.
List of isolates from food samples and identified species by MALDI-TOF/MS score and 16S rRNA identity percentage.
3.2. Resistance to Acid and Bile Salt
The growth profiles in normal (pH 6.5 and 0% bile salt) and under stress conditions (0.5% and 1% bile salt) are illustrated in Figure 2. The LAB strains showed distinct growth profiles in MRS broth at pH 6.5 without bile salt (Figure 2A). Among all isolates, Enterococcus durans was the only strain capable of sustaining growth under simulated gastrointestinal conditions (Figure 2B). Moreover, E. durans exhibited a growth rate of 0.19 h−1; at pH 3.0 supplemented with 0.5% bile salts, compared to 0.07 h−1 at pH 2.5 and 0.5% bile salts (Figure 3).

Figure 2.
Growth profile over 24 h of LAB strains cultivated in (A) normal (pH 6.5 and 0% bile salt) and (B) under acid pH (top line) and acid pH with bile salt 1% (bottom line) stress conditions. Only E. durans grew under these stress conditions (orange line). The initial optical density was ±0.1.

Figure 3.
Growth rate (h−1) of E. durans in a medium simulating gastrointestinal tract condition at pH 2.5 and 3, with varying bile salt concentrations (0.5% and 1%) compared to control condition (pH 6.5). BS: Bile salt. Different lower-case letters indicated significantly different mean values ± SD (n = 3) (p-value < 0.05).
Figure 4 shows the viability of the LAB strains determined after 24 h under normal (control) and stress conditions (pH 3 and 0.5% BS) in MRS broth. Three LAB strains (L. plantarum; E. durans and L. casei) maintained a relatively high survival rate under 0.5% of bile exposure, yet significant inter-strain differences were observed (p < 0.05). Enterococcus durans E21 displayed the highest resilience, retaining more than 80% viability even at 0.5% at bile salts at pH 3, thus confirming its robust gastrointestinal survival potential. Lactiplantibacillus plantarum E17 and L. casei E22 exhibited intermediate tolerance, with survival rates ranging between 70 and 75%. In contrast, L. pseudomesenteroides E18 and L. mesenteroides E19 demonstrated higher sensitivity to these stress conditions.

Figure 4.
Viability (CFU/mL) of 5 LAB at different conditions (pH 3.0 and 0.5% BS and MRS broth pH 6.5 (control) after 24 h of culture. Different lower-case letters indicated significantly different mean values ± SD (n = 3) (p-value < 0.05).
3.3. Surface Hydrophobicity
Figure 5 presents the surface hydrophobicity (%) of the LAB strains as determined by the MATS (Microbial Adhesion to Solvent) assay using toluene as the hydrophobic phase. The results reveal statistically significant differences in hydrophobicity among the tested strains. Enterococcus durans and Lactiplantibacillus plantarum exhibited the highest hydrophobicity values, at 39.2% and 36.8%, respectively, suggesting a strong potential for adherence to hydrophobic surfaces such as intestinal epithelial cells. In contrast, Leuconostoc mesenteroides demonstrated the lowest hydrophobicity, with a value of 14.4%, indicating a comparatively reduced surface adhesion capacity. These inter-strain variations reflect differential cell surface properties that may influence their probiotic efficacy, particularly in terms of mucosal colonization.

Figure 5.
Surface hydrophobicity of LAB strains assessed by measuring the adhesion of PBS-washed cells (pH 7.0) to the hydrophobic solvent toluene (99% purity). Bars labeled with different lowercase letters indicate statistically significant differences in mean values ± SD (n = 3) among strains (p < 0.05), as determined by ANOVA one-way followed by post hoc Tukey test.
3.4. Emulsion Index
The emulsion index (EI) of each strain was assessed at two time points (t = 0 and t = 24 h). As shown in Figure 6, the EI significantly decreased after 24 h for most strains. Notably, Leuconostoc mesenteroides maintained a stable emulsion index over the 24 h period, indicating sustained emulsifying capacity. In contrast, a marked decline in EI was observed for the culture supernatants of Leuconostoc pseudomesenteroides, Lactiplantibacillus plantarum, and Enterococcus durans, suggesting a reduction in emulsion stability over time.

Figure 6.
Emulsion Index at 0 h and after 24 h of cell-free supernatants in presence of toluene (v/v). Bars marked with different lowercase letters indicate statistically significant differences in mean values ± SD (n = 3) (p < 0.05).
3.5. Antibacterial Activity
The evaluation of the antimicrobial activity of tested LAB strains revealed significant differences (p < 0.05) both between species and according to the target pathogen (Table 2). L. mesenteroides (E19) exhibited the highest inhibitory activity against E. coli (21.17 ± 0.36 mm), significantly outperforming the other LAB tested strains. Against B. cereus, L. plantarum (E17) displayed the widest inhibition zone (19.14 ± 1.30 mm), confirming its strong probiotic and antimicrobial potential. Regarding S. epidermidis, the highest inhibition was also observed for L. plantarum (19.11 ± 0.45 mm), followed by L. mesenteroides (16.71 ± 0.51 mm, c3). In contrast, L. pseudomesenteroides (E18) showed no activity against E. coli and B. cereus, and only limited inhibition against S. epidermidis (8.43 ± 0.51 mm). Similarly, E. durans (E21) and L. casei (E22) exerted moderate effects, with inhibition zones ranging from 9.50 ± 1.11 mm to 15.94 ± 0.25 mm depending on the pathogen. Antibacterial activity performed with neutralized cell-free supernatants showed no inhibition spectrum.

Table 2.
Antimicrobial activities of the five LAB species against Bacillus cereus, Staphylococcus epidermidis and E. coli inoculated on MRS agar.
3.6. pH Measurement
To comprehensively assess the metabolic activity of the tested LAB strains, we characterized their acidification kinetics over 48 h (Figure 7). The pH change profile varied notably among the tested strains. L. plantarum (E17) exhibited the fastest and most pronounced acidification, reaching a stable plateau around pH 3.7 within 12 h. L. casei (E22) followed a similar, yet more gradual, trajectory, culminating at pH 4.2. E. durans (E21) showed intermediate acidification, stabilizing around pH 4.1, whereas L. pseudomesenteroides (E18) and L. mesenteroides (E19) displayed the lowest acidifying capacity, with pH remaining above 4.5, even after 24 h.

Figure 7.
Monitoring of pH over 48 h for five LAB strains cultured in MRS broth and incubated at 37 °C with shaking at 150 rpm.
3.7. Organic Acid Production
Organic acid production by LAB species was evaluated using HPLC (Figure 8). Each species exhibited a distinct profile of organic acid production, both in terms of type and concentration. Succinic acid was produced exclusively by two strains, with Leuconostoc mesenteroides generating the highest concentration, approximately 7 g/L. Lactiplantibacillus plantarum demonstrated the greatest capacity for lactic and acetic acid production, with concentrations of approximately 14 g/L and 8 g/L, respectively. Leuconostoc pseudomesenteroides ranked second in lactic acid production and was the only strain capable of synthesizing butyric acid, reaching nearly 5 g/L. In contrast to the other species tested, Enterococcus durans did not produce detectable levels of acetic acid.

Figure 8.
Qualitative and quantitative profiles of organic acids produced by the LAB strains.
3.8. Antibiotic Susceptibility
Antibiotic susceptibility is assessed in this study using a range of common antibiotics. The results presented in Table 3 reveal that all the isolates were sensitive to erythromycin, chloramphenicol, tetracycline and penicillin, whereas L. pseudomesenteroides, L. mesenteroides, E. durans, and L. casei exhibit resistance to streptomycin and kanamycin.

Table 3.
Antibiotic susceptibility profiling of five LAB strains against six antibiotics.
3.9. Hemolytic Activity
The hemolytic activity of the five identified LAB is checked on blood agar compared to both negative (PBS) and positive (Bacillus subtilis BBG258) controls (Figure 9). The results clearly show that no clear zones are observed around all isolates, indicating that all species evaluated were not hemolytic.
Figure 9.
Hemolytic activity assay of five selected LAB compared with positive control (BBG258) and negative control TN (PBS at pH 7). (E17): L. plantarum; (E18): L. pseudomesenteroides; (E19): L. mesenteroides; (E21): E. durans; (E22): L. casei.
4. Discussion
4.1. Identification
In this study, five native LAB isolates (L. plantarum (E17); L. pseudomesenteroides (E18); L. mesenteroides (E19); E. durans (E21); L. casei (E22)) were identified by the MALDI-TOF/MS technique and 16S rRNA sequencing before characterizing their probiotic properties. The selected strains cultivated on solid agar or in liquid medium were identified with scores between 2.02 and 2.37, which were like those obtained with LAB isolated and identified from fish [22].
4.2. Microbial Profiling
Tolerance to gastrointestinal conditions, especially low pH and the presence of bile salt, are recognized as a relevant criterion in the functional characterization of probiotic strains [41]. The results provide critical insights on growth profiles of LAB. Under pH 2.5 or 3.0 and bile salt concentrations of 0.5 or 1%, E. durans demonstrated a notably higher tolerance to acidic stress and bile salt exposure, especially at pH 3 with 0.5% BS, maintaining robust growth through 24 h, consistent with prior findings for E. durans F3 isolated from the gut fresh water fish Catla catla, which survived up to 2% bile salts and pH 3 with minimal viability loss over 6 h [42]. In contrast, L. plantarum, L. pseudomesenteroides, and L. mesenteroides showed limited growth across all conditions, indicating their higher sensitivity to low pH and bile salts. These results suggest strain-specific variations in acid and bile tolerance, which are critical parameters for probiotic selection, especially for strains intended to survive gastrointestinal transit. Several studies have highlighted the importance of acid and bile tolerance in probiotic functionality. For instance, E. durans has previously been reported as a resilient LAB strain capable of surviving gastrointestinal-like conditions, aligning with our results [42,43,44,45]. Similarly, the limited growth observed for Leuconostoc species under stress conditions is highlighted by (Gu et al., 2023), who showed the viability reduction in Leuconostoc mesenteroides under bile salt challenge [46]. These findings emphasize the need for detailed in vitro screening of candidate probiotics before their application in food or therapeutic contexts. Bacteria like E. durans, showing robust growth in low-pH and bile-rich environments, may serve as promising probiotics for functional foods or supplements designed to deliver viable bacteria to the intestines. Its specific growth rate (h−1) under simulated gastrointestinal tract conditions (pH 2.5 and 3.0; bile salts at 0.5% and 1%) showed significant variations (p < 0.05) in growth kinetics depending on the applied physiological stresses. The results demonstrated reduced growth at pH 2.5 compared to pH 3.0, reflecting the detrimental effect of high acidity on bacterial viability, likely due to cellular membrane degradation and metabolic enzyme inactivation [47]. The addition of 1% bile salts increased this inhibition, consistent with mechanisms described in lactobacilli where bile acids disrupt membrane integrity and induce oxidative stress [48,49]. However, the significant differences observed between treatment groups suggest that E. durans possesses partial intrinsic resistance, potentially mediated by efflux pumps or modifications in membrane lipid composition, as observed in Lactiplantibacillus plantarum LM1001, as found by Lee et al., 2024 [50].
In previous works, the stability of a specific strain of E. durans LAB18s has been shown under conditions resembling the intestinal environment, characterized by a pH 3 and the presence of 1% of bile salt [51]. Moreover, it is recognized that Enterococcus genera possess the ability to survive, compete, and adhere to host cells within the gastrointestinal tract (GIT) that is an essential characteristic for their effective application as probiotics. For this reason, Enterococcus strains have been used in the poultry sector due to their ability to produce bacteriocins (enterocins) that are active against Clostridium perfringens [44]. Strains of Enterococcus durans have also been shown to exhibit hydrolytic activity mediated by the enzyme N-acetyltransferase, which facilitates their growth in bile salt-enriched environments, a key probiotic trait associated with gastrointestinal resilience [47,48].
The comparative analysis of bile salt tolerance across the five LAB isolates reveals marked interspecific variability, underscoring the adaptive strategies of individual strains to gastrointestinal stress. Enterococcus durans (E21) exhibited the highest survival rates, maintaining viability above 80% even under 0.5% bile salt conditions, a feature that highlights its remarkable robustness and metabolic adaptability to the hostile gut environment. Such resilience is consistent with previous reports identifying Enterococcus species as strong candidates for colonization of the small intestine due to their intrinsic bile salt hydrolase activity. Conversely, Leuconostoc strains (L. pseudomesenteroides (E18) and L. mesenteroides (E19)) showed high sensitivity, with viability declining completely at the same bile concentrations, reflecting their ecological adaptation to dairy niches where bile stress is absent [52,53]. Interestingly, Lactiplantibacillus plantarum (E17) and L. casei (E22) demonstrated intermediate survival profiles, suggesting strain-dependent variation in membrane fatty [54] acid composition and stress-response gene regulation, both of which have been linked to enhanced probiotic functionality. The overall trend confirms that bile tolerance is not uniformly distributed across LAB species but rather strain-specific and isolates such as E. durans (E21) may therefore constitute promising candidates for probiotic formulations targeting intestinal persistence.
The capacity to inhibit pathogenic germs is an essential property sought in probiotics [54]. Among the five LAB strains tested, four (L. plantarum, L. mesenteroides, E. durans and L. casei) showed an inhibition zone with diameters varying between 9.6 and 21.2 mm around the pathogens Escherichia coli, Staphylococcus epidermidis, and Bacillus cereus. These pathogenic strains were chosen due to their well-documented roles in over 90% of foodborne illnesses [55] and their occurrence in animal pathology [26].
Our results reveal a striking strain- and pathogen-specific antibacterial activity among the tested LAB isolates. The strain L. mesenteroides (E19) exhibited the most potent inhibition against E. coli, while L. plantarum (E17) demonstrated superior activity against both B. cereus and S. epidermidis. Our results are in line with those reported by Koo et al., 2015 [52]. In that study, multiple strains of LAB isolated from ground beef products were evaluated, and only a single strain of Leuconostoc mesenteroides demonstrated enhanced antibacterial activity against Escherichia coli. L. plantarum is well recognized for its ability to synthesize an array of antimicrobial compounds beyond organic acids, including bacteriocins such as plantaricins and other bioactive peptides. On the other hand, the absence of inhibitory activity in L. pseudomesenteroides (E18) against E. coli and B. cereus underscores that not all LAB taxa are inherently antimicrobial highlighting the strain specificity of probiotic efficacy. This variability has been documented in several fermented food-derived LAB isolates, where only a subset exhibited significant antagonistic properties. Furthermore, among 72 LAB strains isolated by Otero et al., 2006 [56], only 2 strains of Lactobacillus gasseri (CRL1421 and CRL1412) were able to show antimicrobial activity against Staphylococcus aureus due to their high production of H2O2 and lactic acid. These results reflect the high functional diversity among LAB, often driven by differential production of organic acids and specialized antimicrobial metabolites [36]. This phenomenon aligns with recent studies highlighting that LAB isolates display variable antagonistic profiles depending on their source, strain identity, and target pathogen [57,58], underlining the necessity of characterizing each strain on a case-by-case basis. The strain E. durans (E21) showed antagonistic effects against E. coli, B. cereus and S. epidermidis, as reported by other authors, based on the inhibition zone diameters, which are larger by 5 to 53% according to the pathogens [50,51]. These recent studies have highlighted the antagonistic potential of Enterococcus strains against major foodborne pathogens, particularly Listeria monocytogenes, Staphylococcus aureus and E. coli, mainly through the production of enterocins and other antimicrobial metabolites.
The species L. casei (E22) inhibited the pathogen E. coli with 15.94 ± 0.25 mm inhibition diameter compared to those found in previous studies (between 10 ± 2 mm to 20 ± 2.5 mm) [59]. The antagonistic power seems to be common in LAB from fermented products as shown by previous studies [60,61]. Neutralized culture supernatants showed no inhibition, indicating that the inhibitory effect of our LAB isolates is primary attributable to acidification, mainly through the production of lactic and acetic acids, rather than bacteriocin secretion. In our study, the total disappearance of inhibition following neutralization strongly suggests an acid-dependent mechanism.
The antimicrobial efficacy of LAB is largely influenced by their metabolic activity, particularly the production of organic acids during this process. Understanding the relationship between acidification kinetics and pathogen inhibition is essential for evaluating their probiotic potential. In this study, we investigated the pH change profiles of several LAB strains and their link with inhibitory effects against common foodborne pathogens. Our results demonstrate that the acidification kinetics of LAB are closely associated with their antimicrobial activity. L. plantarum (E17) exhibited the most rapid and pronounced pH decline, reaching a stable plateau around pH 3.7 within 12 h, and displayed the largest inhibition zones against B. cereus and S. epidermidis. This observation confirms that rapid lactic acid production constitutes a primary mechanism for pathogen inhibition [20,62]. L. casei (E22), which followed a more gradual acidification trajectory culminating at pH 4.2, exhibited moderate inhibition zones, whereas E. durans (E21), with an intermediate final pH of 4.1, also displayed partial inhibitory activity. These findings suggest a dose-dependent relationship between pH reduction and antimicrobial effect, in agreement with Chang et al., 2021, who demonstrated that both the kinetics and magnitude of acidification directly influence the antimicrobial efficacy of LAB [63]. In contrast, L. pseudomesenteroides (E18), whose pH remained above 4.4 even after 24 h, was ineffective against E. coli and B. cereus, confirming that insufficient acidification strongly limits antimicrobial activity. Neutralization of the supernatants abolished the inhibitory effect, further supporting the notion that organic acid production constitutes the primary mechanism of action. Thus, the hierarchy observed in our inhibition assays directly reflects the fast acidification kinetics of strains showing the highest antimicrobial potential, whereas those with slower or limited acidification display reduced inhibitory activity according to the strain of pathogen. These results underscore the importance of considering both the kinetics and magnitude of pH reduction when evaluating the probiotic and antimicrobial potential of LAB.
4.3. Metabolic Profiling
Organic acids are among pathogen-inhibiting metabolites produced by probiotics, especially LAB [64]. The analysis of culture supernatants by HPLC identified nine different organic acids varying in their acid strengths [65] and produced in various concentrations by the five LAB strains. Our study was able to successfully identify a remarkable L. plantarum strain producing a mixture of five organic acids in significant concentrations, such as lactate, acetate, malate, citrate, and propionate, as also demonstrated by other research works [66,67]. This corroborates the antimicrobial efficacy of this strain, as shown in previous studies, on the susceptibility of certain fungi and Gram-negative pathogens to lactic acid producer LAB strains [68,69]. In fact, most of the antimicrobial activities of probiotic strains are associated with their ability to produce and release into their environment, organic acids, including short-chain fatty acids (lactic acid, acetic acid, citric acid, malic acid, oxalic acid, succinic acid, butyric acid, propionic acid, valeric acid) [60,67].
The ability of the LAB isolates to produce other metabolites of interest can also be evaluated indirectly by measuring the functional properties caused by the presence of such bioactive compounds. For instance, the presence of bio-emulsifiers or biosurfactants in the cell-free supernatants is identified by the emulsifying index (EI). This parameter is related to the capacity of the selected strains to produce bio-emulsifiers, capable of solubilizing the hydrophobic phase (e.g., oils, hydrocarbons, etc.), making this carbon source available to microorganisms. This is a useful screening indicator for the competition mechanism of nutrient against pathogens. The LAB supernatant EI was determined just after the emulsification (t ~ 0) (EI0) and after 24 h (EI24), indicating the emulsifying capacity and stability of the supernatant content, respectively. The difference in EI0 of the selected LAB indicates a variability in the capacity of the supernatant to disperse the oil phase in the continuous aqueous phase. However, EI24 is quite similar for all selected LAB, indicating an equivalent power of the different strains in producing emulsion stabilizers. The ratio EI24*100/EI0 is another indicator of emulsion stability that is correlated to the rate of emulsion destabilization.
4.4. Safety
In this work, safety has been assessed by testing the sensitivity to antibiotics and hemolysis for all LAB strains, even though whole-genome sequencing was necessary to potentially identify genes associated with certain Enterococcus [70].
The assessment of antibiotic susceptibility represents a critical safety criterion for LAB prior to their selection as potential probiotic strains [64]. In the present study, phenotypic profiling of the isolated LAB strains revealed distinct antibiotic susceptibility patterns. Except for L. plantarum, all the isolates exhibited pronounced sensitivity to erythromycin, with inhibition zones exceeding 28 mm; notably, L. pseudomesenteroides demonstrated an exceptionally large zone (39.3 mm) suggesting a low risk of resistance gene transfer for these antibiotics. Conversely, L. plantarum, E. durans, and L. casei exhibited intrinsic resistance to streptomycin (0 mm), while Leuconostoc strains showed moderate to high sensitivity. All the strains demonstrated strong sensitivity to chloramphenicol (>21 mm). This is consistent with the previous studies where 96.9% of the 65 LAB tested were highly susceptible to chloramphenicol [71]. Tetracycline exhibited the broadest inhibitory range (21.0–40.7 mm), with L. pseudomesenteroides again most susceptible. While tetracycline resistance genes (e.g., tetM, tetW and tetL) have been sporadically detected in LAB from fermented foods, the absence of phenotypic resistance in our isolates suggests either low gene prevalence or non-functional expression, corroborating recent phenotypic surveys [72]. Penicillin efficacy was uniformly high, particularly against L. pseudomesenteroides and L. mesenteroides, consistent with the well-documented intrinsic sensitivity of LAB to β-lactams due to peptidoglycan-targeted cell wall biosynthetic pathways [73,74]. Resistance to kanamycin (≤14 mm) was noted in L. plantarum, E. durans, and L. casei, a pattern widely reported as intrinsic, non-transmissible aminoglycoside resistance in LAB and deemed acceptable under EFSA criteria [75]. Our results are in line with those of previous studies, who observed the high resistance of LAB to kanamycin (32.3%) [71]. In summary, none of the strains displayed acquired or multidrug resistance. Their maintained susceptibility to relevant antibiotics erythromycin, chloramphenicol, tetracycline, and penicillin confirm their safety profile for food and feed applications. The observed resistance to aminoglycosides (Erythromycin and streptomycin), being intrinsic (with the resistance genes (aac(6′)-aph(2”), ant(6) and aph(3′)-IIIa) and non-acquired, poses no regulatory concern under current probiotic strain selection frameworks, as described by Wong et al., 2015 [73].
In accordance with the recommendations of the European Food Safety Authority (EFSA), the assessment of hemolytic activity is highly advised for bacterial strains intended for use in food products, regardless of their GRAS or QPS status [76]. In the present study, the hemolytic activity of five bacterial isolates was assessed using Columbia blood agar plates. None of the tested strains exhibited α-hemolytic or β-hemolytic activity but demonstrated γ-hemolytic behavior. The results of this work aligned with those reported in other investigations that suggest no hemolytic activities were found in eight Lactiplantibacillus species isolated from fermented millet-based alcoholic beverages [77]. The safety property of LAB isolated from fermented non-dairy food products in China was evaluated in other studies, which revealed no evidence of hemolytic activity for these bacteria [74]. The five strains isolated in this present study were, therefore, not involved in the lysis of erythrocytes as shown by several studies reporting that probiotics need to exhibit no hemolytic activity [71,78].
5. Conclusions
This study, which focused on the performance assessment of probiotic strains from Moroccan traditional foods, shows the potential of dairy fermented products widely consumed by the local population to contain beneficial microbes for diverse applications. Five isolated LAB strains doubly identified by 16S rRNA sequencing and MALDI-TOF techniques reveal potential probiotic properties, especially for their robustness to survive under bile and acid stress conditions (L. plantarum, L. casei, and E. durans), and for their capacity to release a high number of multiple organic acids (L. plantarum). Their safety is shown by the absence of hemolysis and resistance to common antibiotics. Such results support their potential use as additives for sustainable animal farming. Other strains of isolates from West African countries are now under investigation.
Author Contributions
Conceptualization, H.R., P.J., Draft writing, A.O.P.Y., Review and Editing, H.R., P.J., M.M.; Experimentation and data processing, A.O.P.Y. All authors have read and agreed to the published version of the manuscript.
Funding
This work has received funding from the European Union’s Horizon Europe Research, innovation program through URBANE under the grant Agreement 101059232. A.O.P.Y. received a grant from Ivory Coast guidance and scholarships department for his master’s degree.
Institutional Review Board Statement
Not applicable.
Informed Consent Statement
Not applicable.
Data Availability Statement
The original contributions presented in this study are included in the article. Further inquiries can be directed to the corresponding author.
Conflicts of Interest
The authors declare no conflicts of interest.
References
- Fanzo, J.; Bellows, A.L.; Spiker, M.L.; Thorne-Lyman, A.L.; Bloem, M.W. The importance of food systems and the environment for nutrition. Am. J. Clin. Nutr. 2021, 113, 7–16. [Google Scholar] [CrossRef]
- Silva, V.; Mol, H.G.J.; Zomer, P.; Tienstra, M.; Ritsema, C.J.; Geissen, V. Pesticide residues in European agricultural soils—A hidden reality unfolded. Sci. Total Environ. 2019, 653, 1532–1545. [Google Scholar] [CrossRef]
- Liu, X.; Steele, J.C.; Meng, X.-Z. Usage, residue, and human health risk of antibiotics in Chinese aquaculture: A review. Environ. Pollut. 2017, 223, 161–169. [Google Scholar] [CrossRef]
- Lai, W.W.-P.; Lin, Y.-C.; Wang, Y.-H.; Guo, Y.L.; Lin, A.Y.-C. Occurrence of emerging contaminants in aquaculture waters: Cross-contamination between aquaculture systems and surrounding waters. Water Air Soil. Pollut. 2018, 229, 249. [Google Scholar] [CrossRef]
- Long, D. FDA Rejections of Antibiotic Contaminated Indian Shrimp Continue in September—Southern Shrimp Alliance 2018. Available online: https://shrimpalliance.com/fda-rejections-of-antibiotic-contaminated-indian-shrimp-continue-in-september/ (accessed on 4 October 2018).
- Anderson, A.J.; Kim, Y.C. Biopesticides produced by plant-probiotic Pseudomonas chlororaphis isolates. Crop Prot. 2018, 105, 62–69. [Google Scholar] [CrossRef]
- Cuong, N.V.; Kiet, B.T.; Hien, V.B.; Truong, B.D.; Phu, D.H.; Thwaites, G.; Choisy, M.; Carrique-Mas, J. Antimicrobial use through consumption of medicated feeds in chicken flocks in the mekong delta of vietnam: A three-year study before a ban on antimicrobial growth promoters. PLoS ONE 2021, 16, e0250082. [Google Scholar] [CrossRef] [PubMed]
- Manyi-Loh, C.; Mamphweli, S.; Meyer, E.; Okoh, A. Antibiotic use in agriculture and its consequential resistance in environmental sources: Potential public health implications. Molecules 2018, 23, 795. [Google Scholar] [CrossRef]
- Okaiyeto, S.A.; Sutar, P.P.; Chen, C.; Ni, J.-B.; Wang, J.; Mujumdar, A.S.; Zhang, J.-S.; Xu, M.-Q.; Fang, X.-M.; Zhang, C.; et al. Antibiotic resistant bacteria in food systems: Current status, resistance mechanisms, and mitigation strategies. Agric. Commun. 2024, 2, 100027. [Google Scholar] [CrossRef]
- Hill, C.; Guarner, F.; Reid, G.; Gibson, G.R.; Merenstein, D.J.; Pot, B.; Morelli, L.; Canani, R.B.; Flint, H.J.; Salminen, S.; et al. Expert Consensus Document. The international scientific association for probiotics and prebiotics consensus statement on the scope and appropriate use of the term probiotic. Nat. Rev. Gastroenterol. Hepatol. 2014, 11, 506–514. [Google Scholar] [CrossRef]
- Ayeni, F.A.; Sánchez, B.; Adeniyi, B.A.; de Los Reyes-Gavilán, C.G.; Margolles, A.; Ruas-Madiedo, P. Evaluation of the functional potential of Weissella and Lactobacillus isolates obtained from nigerian traditional fermented foods and cow’s intestine. Int. J. Food Microbiol. 2011, 147, 97–104. [Google Scholar] [CrossRef] [PubMed]
- Kassa, G.; Alemayehu, D.; Andualem, B. Isolation, identification, and molecular characterization of probiotic bacteria from locally selected ethiopian free range chickens gastrointestinal tract. Poult. Sci. 2024, 103, 103311. [Google Scholar] [CrossRef]
- Fontana, L.; Bermudez-Brito, M.; Plaza-Diaz, J.; Muñoz-Quezada, S.; Gil, A. Sources, isolation, characterisation and evaluation of probiotics. Br. J. Nutr. 2013, 109, S35–S50. [Google Scholar] [CrossRef] [PubMed]
- Kaur, S.; Kaur, R.; Rani, N.; Sharma, S.; Joshi, M. Sources and selection criteria of probiotics. In Advances in Probiotics for Sustainable Food and Medicine; Goel, G., Kumar, A., Eds.; Springer: Singapore, 2021; pp. 27–43. ISBN 978-981-15-6795-7. [Google Scholar]
- Obafemi, Y.D.; Oranusi, S.U.; Ajanaku, K.O.; Akinduti, P.A.; Leech, J.; Cotter, P.D. African fermented foods: Overview, emerging benefits, and novel approaches to microbiome profiling. npj Sci. Food 2022, 6, 15. [Google Scholar] [CrossRef]
- Tamang, J.P.; Cotter, P.D.; Endo, A.; Han, N.S.; Kort, R.; Liu, S.Q.; Mayo, B.; Westerik, N.; Hutkins, R. Fermented foods in a global age: East meets west. Compr. Rev. Food Sci. Food Saf. 2020, 19, 184–217. [Google Scholar] [CrossRef] [PubMed]
- Salem, H.; Kaltenpoth, M. The nagoya protocol and its implications for microbiology. Nat. Microbiol. 2023, 8, 2234–2237. [Google Scholar] [CrossRef]
- Tharmaraj, N.; Shah, N.P. Selective enumeration of Lactobacillus delbrueckii ssp. bulgaricus, Streptococcus thermophilus, Lactobacillus acidophilus, Bifidobacteria, Lactobacillus casei, Lactobacillus rhamnosus, and Propionibacteria. J. Dairy Sci. 2003, 86, 2288–2296. [Google Scholar] [CrossRef] [PubMed]
- Ołdak, A.; Zielińska, D.; Rzepkowska, A.; Kołożyn-Krajewska, D. Comparison of antibacterial activity of Lactobacillus Plantarum strains isolated from two different kinds of regional cheeses from Poland: Oscypek and korycinski cheese. BioMed Res. Int. 2017, 2017, 6820369. [Google Scholar] [CrossRef]
- Sadeghi, M.; Panahi, B.; Mazlumi, A.; Hejazi, M.A.; Komi, D.E.A.; Nami, Y. Screening of potential probiotic lactic acid bacteria with antimicrobial properties and selection of superior bacteria for application as biocontrol using machine learning models. LWT 2022, 162, 113471. [Google Scholar] [CrossRef]
- Johnson, J.S.; Spakowicz, D.J.; Hong, B.-Y.; Petersen, L.M.; Demkowicz, P.; Chen, L.; Leopold, S.R.; Hanson, B.M.; Agresta, H.O.; Gerstein, M.; et al. Evaluation of 16S rRNA gene sequencing for species and strain-level microbiome analysis. Nat. Commun. 2019, 10, 5029. [Google Scholar] [CrossRef]
- Blondiaux, N.; Gaillot, O.; Courcol, R.-J. Identification bactérienne par spectrométrie de masse de type MALDI-TOF: Évaluation au CHU de Lille. Pathol. Biol. 2010, 58, 55–57. [Google Scholar] [CrossRef]
- Nacef, M.; Chevalier, M.; Chollet, S.; Drider, D.; Flahaut, C. MALDI-TOF mass spectrometry for the identification of lactic acid bacteria isolated from a french cheese: The maroilles. Int. J. Food Microbiol. 2017, 247, 2–8. [Google Scholar] [CrossRef]
- Wejinya, A.O.; Giami, S.Y.; Barber, L.I.; Obinna-Echem, P.C. Isolation, identification and characterization of potential probiotics from fermented food products. Asian Food Sci. J. 2022, 14–25. [Google Scholar] [CrossRef]
- Sakoui, S.; Derdak, R.; Pop, O.L.; Vodnar, D.C.; Jouga, F.; Teleky, B.-E.; Addoum, B.; Simon, E.; Suharoschi, R.; Soukri, A.; et al. Exploring technological, safety and probiotic properties of Enterococcus strains: Impact on rheological parameters in fermented milk. Foods 2024, 13, 586. [Google Scholar] [CrossRef]
- Vaillant, V.; Valk, H.D.; Baron, E.; Ancelle, T.; Colin, P.; Delmas, M.-C.; Dufour, B.; Pouillot, R.; Strat, Y.L.; Weinbreck, P.; et al. Foodborne infections in France. Foodborne Pathog. Dis. 2005, 2, 221–232. [Google Scholar] [CrossRef]
- Jiang, Z.; Yang, M.; Su, W.; Mei, L.; Li, Y.; Guo, Y.; Li, Y.; Liang, W.; Yang, B.; Huang, Z.; et al. Probiotics in piglet: From gut health to pathogen defense mechanisms. Front. Immunol. 2024, 15. [Google Scholar] [CrossRef] [PubMed]
- Arrioja-Bretón, D.; Mani-López, E.; Palou, E.; López-Malo, A. Antimicrobial activity and storage stability of cell-free supernatants from lactic acid bacteria and their applications with fresh beef. Food Control 2020, 115, 107286. [Google Scholar] [CrossRef]
- Rosenberg, M.; Gutnick, D.; Rosenberg, E. Adherence of bacteria to hydrocarbons: A simple method for measuring cell-surface hydrophobicity. FEMS Microbiol. Lett. 1980, 9, 29–33. [Google Scholar] [CrossRef]
- Ahimou, F.; Paquot, M.; Jacques, P.; Thonart, P.; Rouxhet, P.G. Influence of electrical properties on the evaluation of the surface hydrophobicity of Bacillus subtilis. J. Microbiol. Methods 2001, 45, 119–126. [Google Scholar] [CrossRef] [PubMed]
- Rühs, P.A.; Böcker, L.; Inglis, R.F.; Fischer, P. Studying bacterial hydrophobicity and biofilm formation at liquid–liquid interfaces through interfacial rheology and pendant drop tensiometry. Colloids Surf. B Biointerfaces 2014, 117, 174–184. [Google Scholar] [CrossRef] [PubMed]
- Calvigioni, M.; Bertolini, A.; Codini, S.; Mazzantini, D.; Panattoni, A.; Massimino, M.; Celandroni, F.; Zucchi, R.; Saba, A.; Ghelardi, E. HPLC-MS-MS quantification of short-chain fatty acids actively secreted by probiotic strains. Front. Microbiol. 2023, 14. [Google Scholar] [CrossRef]
- Díaz-Corona, L.R.; Parra-Saavedra, K.J.; Mora-Alonzo, R.S.; Macías-Rodríguez, M.E.; Martínez-Preciado, A.H.; Guevara-Martínez, S.J.; Zamudio-Ojeda, A.; Macias-Lamas, A.M. HPLC-DAD development and validation method for short-chain fatty acids quantification from chicken feces by solid-phase extraction. Separations 2023, 10, 308. [Google Scholar] [CrossRef]
- Prasanna, P.H.P.; Bell, A.; Grandison, A.S.; Charalampopoulos, D. Emulsifying, rheological and physicochemical properties of exopolysaccharide produced by Bifidobacterium longum subsp. infantis CCUG 52486 and Bifidobacterium infantis NCIMB 702205. Carbohydr. Polym. 2012, 90, 533–540. [Google Scholar] [CrossRef]
- Ma, W. Performance Standards for Antimicrobial Susceptibility Testing Sixteenth Informational Supplement. M 100-S 16. 2006. Available online: https://cir.nii.ac.jp/crid/1570572701037441792 (accessed on 31 October 2023).
- Moreno, I.; Marasca, E.T.G.; de Sá, P.B.Z.R.; de Souza Moitinho, J.; Marquezini, M.G.; Alves, M.R.C.; Bromberg, R. Evaluation of probiotic potential of bacteriocinogenic lactic acid bacteria strains isolated from meat products. Probiotics Antimicrob. Proteins 2018, 10, 762–774. [Google Scholar] [CrossRef] [PubMed]
- Zhang, Q.; Wang, M.; Ma, X.; Li, Z.; Jiang, C.; Pan, Y.; Zeng, Q. In vitro investigation on lactic acid bacteria isolated from yak faeces for potential probiotics. Front. Cell. Infect. Microbiol. 2022, 12. [Google Scholar] [CrossRef]
- Yaseen, Y.; Diop, A.; Gancel, F.; Béchet, M.; Jacques, P.; Drider, D. Polynucleotide phosphorylase is involved in the control of lipopeptide fengycin production in Bacillus subtilis. Arch. Microbiol. 2018, 200, 783–791. [Google Scholar] [CrossRef]
- Yasmin, I.; Saeed, M.; Khan, W.A.; Khaliq, A.; Chughtai, M.F.J.; Iqbal, R.; Tehseen, S.; Naz, S.; Liaqat, A.; Mehmood, T.; et al. In vitro probiotic potential and safety evaluation (hemolytic, cytotoxic activity) of bifidobacterium strains isolated from raw camel milk. Microorganisms 2020, 8, 354. [Google Scholar] [CrossRef]
- Morelli, L.; Capurso, L. FAO/WHO Guidelines on Probiotics: 10 Years Later. J. Clin. Gastroenterol. 2012, 46, S1. [Google Scholar] [CrossRef]
- Riegel, P.; Briel, D.d.; Dauwalder, O. Automatisation de l’identification bactérienne. Rev. Francoph. Des. Lab. 2016, 2016, 39–47. [Google Scholar] [CrossRef]
- Alshammari, E.; Patel, M.; Sachidanandan, M.; Kumar, P.; Adnan, M. Potential evaluation and health fostering intrinsic traits of novel probiotic strain Enterococcus durans F3 isolated from the gut of fresh water fish Catla catla. Food Sci. Anim. Resour. 2019, 39, 844–861. [Google Scholar] [CrossRef] [PubMed]
- Zhou, Y.; Shi, L.; Wang, J.; Yuan, J.; Liu, J.; Liu, L.; Da, R.; Cheng, Y.; Han, B. Probiotic potential analysis and safety evaluation of Enterococcus durans A8-1 isolated from a healthy chinese infant. Front. Microbiol. 2021, 12, 799173. [Google Scholar] [CrossRef]
- García-Vela, S.; Ben Said, L.; Soltani, S.; Guerbaa, R.; Fernández-Fernández, R.; Ben Yahia, H.; Ben Slama, K.; Torres, C.; Fliss, I. Targeting Enterococci with antimicrobial activity against clostridium perfringens from poultry. Antibiotics 2023, 12, 231. [Google Scholar] [CrossRef]
- Pristavu, M.-C.; Diguță, F.C.; Aldea, A.C.; Badea, F.; Dragoi Cudalbeanu, M.; Ortan, A.; Matei, F. Functional profiling of Enterococcus and Pediococcus strains: An in vitro study on probiotic and postbiotic properties. Microorganisms 2025, 13, 1348. [Google Scholar] [CrossRef]
- Gu, M.; Nguyen, H.T.; Cho, J.-H.; Suh, J.-W.; Cheng, J. Characterization of Leuconostoc mesenteroides MJM60376 as an oral probiotic and its antibiofilm activity. Mol. Oral. Microbiol. 2023, 38, 145–157. [Google Scholar] [CrossRef]
- Franz, C.M.; Specht, I.; Haberer, P.; Holzapfel, W.H. Bile Salt hydrolase activity of Enterococci isolated from food: Screening and quantitative determination. J. Food Prot. 2001, 64, 725–729. [Google Scholar] [CrossRef]
- Rimal, B.; Collins, S.L.; Tanes, C.E.; Rocha, E.R.; Granda, M.A.; Solanki, S.; Hoque, N.J.; Gentry, E.C.; Koo, I.; Reilly, E.R.; et al. Bile Salt hydrolase catalyses formation of amine-conjugated bile acids. Nature 2024, 626, 859–863. [Google Scholar] [CrossRef] [PubMed]
- Rashid, H.; Anwar, H.; Baig, F.M.; Mukhtar, I.; Muhammad, T.; Zaidi, A. Potentially Probiotic NPL 1334 Strain of Enterococcus durans benefits rats with diet-induced hypercholesterolemia. BMC Biotechnol. 2025, 25. [Google Scholar] [CrossRef] [PubMed]
- Lee, M.-G.; Kang, M.J.; Cha, S.; Kim, T.-R.; Park, Y.-S. Acid tolerance responses and their mechanisms in Lactiplantibacillus plantarum LM1001. Food Sci. Biotechnol. 2024, 33, 2213–2222. [Google Scholar] [CrossRef]
- Pieniz, S.; Andreazza, R.; Anghinoni, T.; Camargo, F.; Brandelli, A. Probiotic potential, antimicrobial and antioxidant activities of Enterococcus Durans Strain LAB18s. Food Control 2014, 37, 251–256. [Google Scholar] [CrossRef]
- Koo, O.K.; Kim, S.M.; Kang, S.-H. Antimicrobial potential of Leuconostoc Species against E. coli O157:H7 in ground meat. J. Korean Soc. Appl. Biol. Chem. 2015, 58, 831–838. [Google Scholar] [CrossRef]
- Wang, Y.; Li, A.; Jiang, X.; Zhang, H.; Mehmood, K.; Zhang, L.; Jiang, J.; Waqas, M.; Iqbal, M.; Li, J. Probiotic potential of Leuconostoc pseudomesenteroides and Lactobacillus strains isolated from yaks. Front. Microbiol. 2018, 9, 2987. [Google Scholar] [CrossRef]
- Neal-McKinney, J.M.; Lu, X.; Duong, T.; Larson, C.L.; Call, D.R.; Shah, D.H.; Konkel, M.E. Production of organic acids by probiotic Lactobacilli can be used to reduce pathogen Load in Poultry. PLoS ONE 2012, 7, e43928. [Google Scholar] [CrossRef]
- Berebon, D.; Ofokansi, K.; Attama, A.; Eze, C.; Onwusoba, R.; Ugwoke, I. Preliminary studies on isolation, bile tolerance and antibiogram of potential probiotics (probionts) from locally fermented food products at beach market, nsukka metropolis, enugu state, nigeria. Biotechnol. J. Int. 2019, 1–10. [Google Scholar] [CrossRef]
- Otero, M.C.; Nader-Macías, M.E. Inhibition of Staphylococcus aureus by H2O2-producing Lactobacillus gasseri isolated from the vaginal tract of cattle. Anim. Reprod. Sci. 2006, 96, 35–46. [Google Scholar] [CrossRef] [PubMed]
- Fukuda, S.; Toh, H.; Hase, K.; Oshima, K.; Nakanishi, Y.; Yoshimura, K.; Tobe, T.; Clarke, J.M.; Topping, D.L.; Suzuki, T.; et al. Bifidobacteria can protect from enteropathogenic infection through production of acetate. Nature 2011, 469, 543–547. [Google Scholar] [CrossRef]
- Sharma, A.; Lee, H.-J. Antimicrobial activity of probiotic bacteria isolated from plants: A review. Foods 2025, 14, 495. [Google Scholar] [CrossRef]
- Chahrazed, B.; Souhila, A.; Amine, B.; Mohamed, Z.L. Etude du potentiel probiotique des bacteries. Alger. J. Arid. Environ. 2021, 11, 10. [Google Scholar]
- Gaggìa, F.; Mattarelli, P.; Biavati, B. Probiotics and prebiotics in animal feeding for safe food production. Int. J. Food Microbiol. 2010, 141, S15–S28. [Google Scholar] [CrossRef]
- Lauková, A.; Kandričáková, A.; Buňková, L.; Pleva, P.; Ščerbová, J. Sensitivity to enterocins of biogenic amine-producing faecal enterococci from ostriches and pheasants. Probiotics Antimicro. Prot. 2017, 9, 483–491. [Google Scholar] [CrossRef]
- Hossain, T.J.; Mozumder, H.A.; Ali, F.; Akther, K. Inhibition of pathogenic microbes by the lactic acid bacteria Limosilactobacillus fermentum strain lab-1 and Levilactobacillus brevis strain lab-5 isolated from the dairy beverage borhani. Curr. Res. Nutr. Food Sci. 2022, 10, 928–939. [Google Scholar] [CrossRef]
- Chang, H.M.; Foo, H.L.; Loh, T.C.; Lim, E.T.C.; Abdul Mutalib, N.E. Comparative studies of inhibitory and antioxidant activities, and organic acids compositions of postbiotics produced by probiotic Lactiplantibacillus plantarum strains isolated from malaysian foods. Front. Vet. Sci. 2021, 7. [Google Scholar] [CrossRef]
- Tejero-Sariñena, S.; Barlow, J.; Costabile, A.; Gibson, G.R.; Rowland, I. In vitro evaluation of the antimicrobial activity of a range of probiotics against pathogens: Evidence for the effects of organic acids. Anaerobe 2012, 18, 530–538. [Google Scholar] [CrossRef]
- Barlin, G.B.; Perrin, D.D. Prediction of the strengths of organic acids. Q. Rev. Chem. Soc. 1966, 20, 75–101. [Google Scholar] [CrossRef]
- Punia Bangar, S.; Suri, S.; Trif, M.; Ozogul, F. Organic acids production from lactic acid bacteria: A preservation approach. Food Biosci. 2022, 46, 101615. [Google Scholar] [CrossRef]
- Rocha-Ramírez, L.M.; Hernández-Chiñas, U.; Moreno-Guerrero, S.S.; Ramírez-Pacheco, A.; Eslava, C.A. In vitro Effect of the cell-free supernatant of the Lactobacillus casei Strain IMAU60214 against the different pathogenic properties of diarrheagenic Escherichia coli. Microorganisms 2023, 11, 1324. [Google Scholar] [CrossRef]
- Guimarães, A.; Santiago, A.; Teixeira, J.A.; Venâncio, A.; Abrunhosa, L. Anti-Aflatoxigenic effect of organic acids produced by Lactobacillus plantarum. Int. J. Food Microbiol. 2018, 264, 31–38. [Google Scholar] [CrossRef]
- Song, J. Functional Properties of Probiotics in Food Sources. Foods 2024, 13, 2548. [Google Scholar] [CrossRef]
- Jaimee, G.; Halami, P. Emerging resistance to aminoglycosides in lactic acid bacteria of food origin-an impending menace. Appl. Microbiol. Biotechnol. 2016, 100. [Google Scholar] [CrossRef] [PubMed]
- Stefańska, I.; Kwiecień, E.; Jóźwiak-Piasecka, K.; Garbowska, M.; Binek, M.; Rzewuska, M. Antimicrobial susceptibility of lactic acid bacteria strains of potential use as feed additives-the basic safety and usefulness criterion. Front. Vet. Sci. 2021, 8. [Google Scholar] [CrossRef]
- Anisimova, E.A.; Yarullina, D.R. Antibiotic resistance of Lactobacillus strains. Curr. Microbiol. 2019, 76, 1407–1416. [Google Scholar] [CrossRef]
- Wong, A.; Ngu, D.Y.S.; Dan, L.A.; Ooi, A.; Lim, R.L.H. Detection of antibiotic resistance in probiotics of dietary supplements. Nutr. J. 2015, 14, 95. [Google Scholar] [CrossRef] [PubMed]
- Binda, S.; Hill, C.; Johansen, E.; Obis, D.; Pot, B.; Sanders, M.E.; Tremblay, A.; Ouwehand, A.C. Criteria to qualify microorganisms as “probiotic” in foods and dietary supplements. Front. Microbiol. 2020, 11, 1662. [Google Scholar] [CrossRef]
- EFSA Panel on Additives and Products or Substances used in Animal Feed (FEEDAP). Guidance on the Assessment of Bacterial Susceptibility to Antimicrobials of Human and Veterinary Importance. EFS2 2012, 10. [Google Scholar] [CrossRef]
- EFSA Panel on Additives and Products or Substances used in Animal Feed (FEEDAP); Rychen, G.; Aquilina, G.; Azimonti, G.; Bampidis, V.; Bastos, M.d.L.; Bories, G.; Chesson, A.; Cocconcelli, P.S.; Flachowsky, G.; et al. Guidance on the Identity, Characterisation and Conditions of Use of Feed Additives. EFSA J. 2017, 15, e05023. [Google Scholar] [CrossRef] [PubMed]
- Wang, J.; Wang, J.; Yang, K.; Liu, M.; Zhang, J.; Wei, X.; Fan, M. Screening for potential probiotic from spontaneously fermented non-dairy foods based on in vitro probiotic and safety properties. Ann. Microbiol. 2018, 68, 803–813. [Google Scholar] [CrossRef]
- Rychen, G.; Aquilina, G.; Azimonti, G.; Bampidis, V.; Bastos, M.d.L.; Bories, G.; Chesson, A.; Cocconcelli, P.S.; Flachowsky, G.; Gropp, J.; et al. Guidance on the characterisation of microorganisms used as feed additives or as production organisms. EFSA J. 2018, 16, e05206. [Google Scholar] [CrossRef] [PubMed]
Disclaimer/Publisher’s Note: The statements, opinions and data contained in all publications are solely those of the individual author(s) and contributor(s) and not of MDPI and/or the editor(s). MDPI and/or the editor(s) disclaim responsibility for any injury to people or property resulting from any ideas, methods, instructions or products referred to in the content. |
© 2025 by the authors. Licensee MDPI, Basel, Switzerland. This article is an open access article distributed under the terms and conditions of the Creative Commons Attribution (CC BY) license (https://creativecommons.org/licenses/by/4.0/).